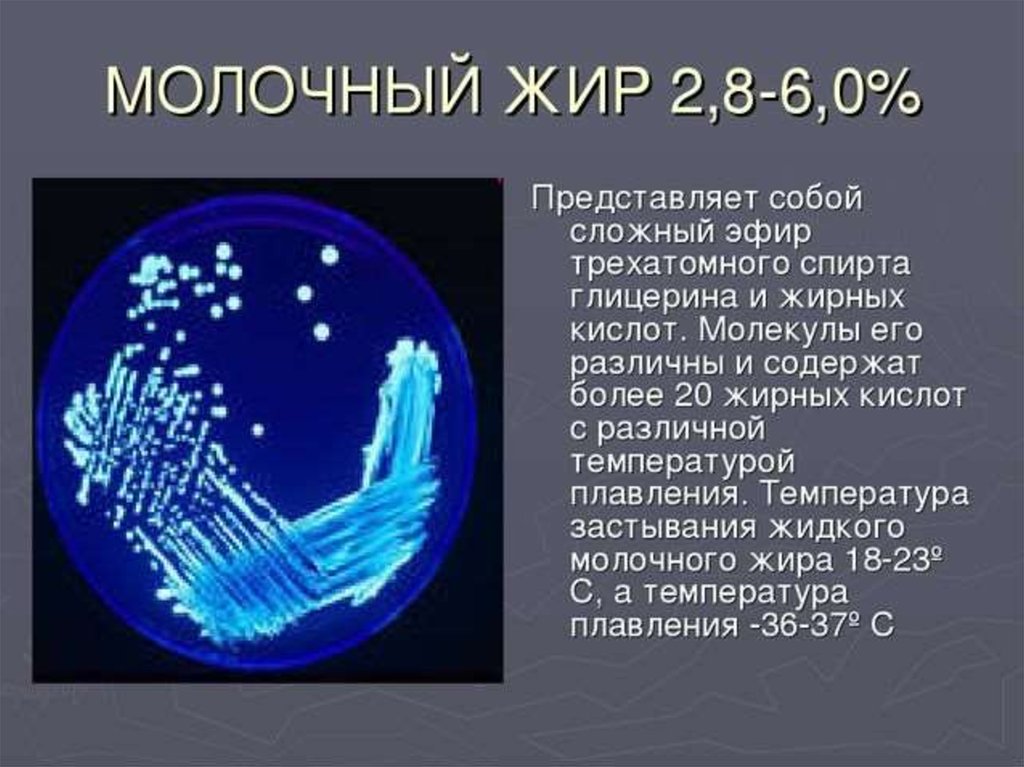

Similar presentations:
Химический состав молока
1. Презентация на тему: «Химический состав молока»
Выполнил: Монгуш Э.МПроверила: Тыхенова О.Г
2.
Молоко – уникальныйпо составу и свойствам
природный продукт.
Кроме того, это сырье
для производства
огромного количества
пищевых товаров,
которые мы
употребляем с
большим
удовольствием и
пользой для здоровья.

chemistry
chemistry








